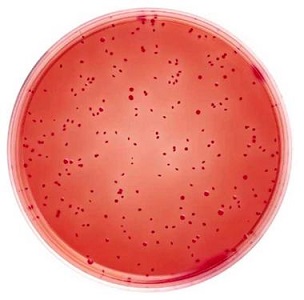
结晶紫中性红胆盐琼脂

结晶紫中性红胆盐琼脂
Violet Red Bile Agar
询价
1瓶
起订
广东 更新日期:2026-04-05
产品详情:
- 中文名称:
- 结晶紫中性红胆盐琼脂
- 英文名称:
- Violet Red Bile Agar
- 保存条件:
- 2~8℃,避光储存,拆封后及时放入冰箱冷藏;
- 产品类别:
- 培养基
- 用途:
- 用于大肠菌群的固体平板检测(SN标准)
- 保质期:
- 6个月-1年。
- 规格:
- 250g/瓶
公司简介
深圳子科生物科技有限公司经过专业化技术研发团队、科研销售团队不懈的努力和坚持已迅速成为集科研、生产、销售为一体的专业化生物工程公司,是国内各大重点实验室指定合作单位,拥有专业的实验室、先进的实验仪器设备和经验丰富的科研技术人员,技术团队包括博士后研究员2名,博士助理研究员2名,硕士核心研究员16人,可以有效的保证公司产品强的稳定性和高的准确性,我公司客户群体已经覆盖了全国二十三个省市的上下游企业、高校实验室、省市级研究所、研究院等等,公司始终坚持不懈地跟踪最新科研方向,掌控最新国际前沿科学新技术,不断进取,为广大客户提供最好、最快的服务和优质产品而不懈努力。
| 成立日期 | (11年) |
| 注册资本 | 50万人民币 |
| 员工人数 | 10-50人 |
| 年营业额 | ¥ 100万-300万 |
| 经营模式 | 工厂,试剂,定制 |
| 主营行业 | 生物化工 |
结晶紫中性红胆盐琼脂相关厂家报价 更多
-

- 结晶紫中性红胆盐琼脂
- 上海康朗生物科技有限公司 VIP
- 2026-04-03
- ¥150
-
![结晶紫中性红胆盐琼脂培养基基础[含葡萄糖和乳糖]](https://img.chemicalbook.com/SupplyImg/2021-04-23/Large/202104231056344172196.jpg)
- 结晶紫中性红胆盐琼脂培养基基础[含葡萄糖和乳糖]
- 上海冠导生物工程有限公司 VIP
- 2026-04-10
- 询价
-
![结晶紫中性红胆盐琼脂培养基基础[含葡萄糖和乳糖]](https://img.chemicalbook.com/SupplyImg/2020-06-07/Large/202006071131293402997.jpg)
- 结晶紫中性红胆盐琼脂培养基基础[含葡萄糖和乳糖]
- 上海宾穗生物科技有限公司 VIP
- 2026-04-10
- ¥681
-

- 结晶紫 分析纯结晶紫 试剂级结晶紫 高纯结晶紫
- 廊坊乾耀科技有限公司 VIP
- 2026-04-10
- 询价